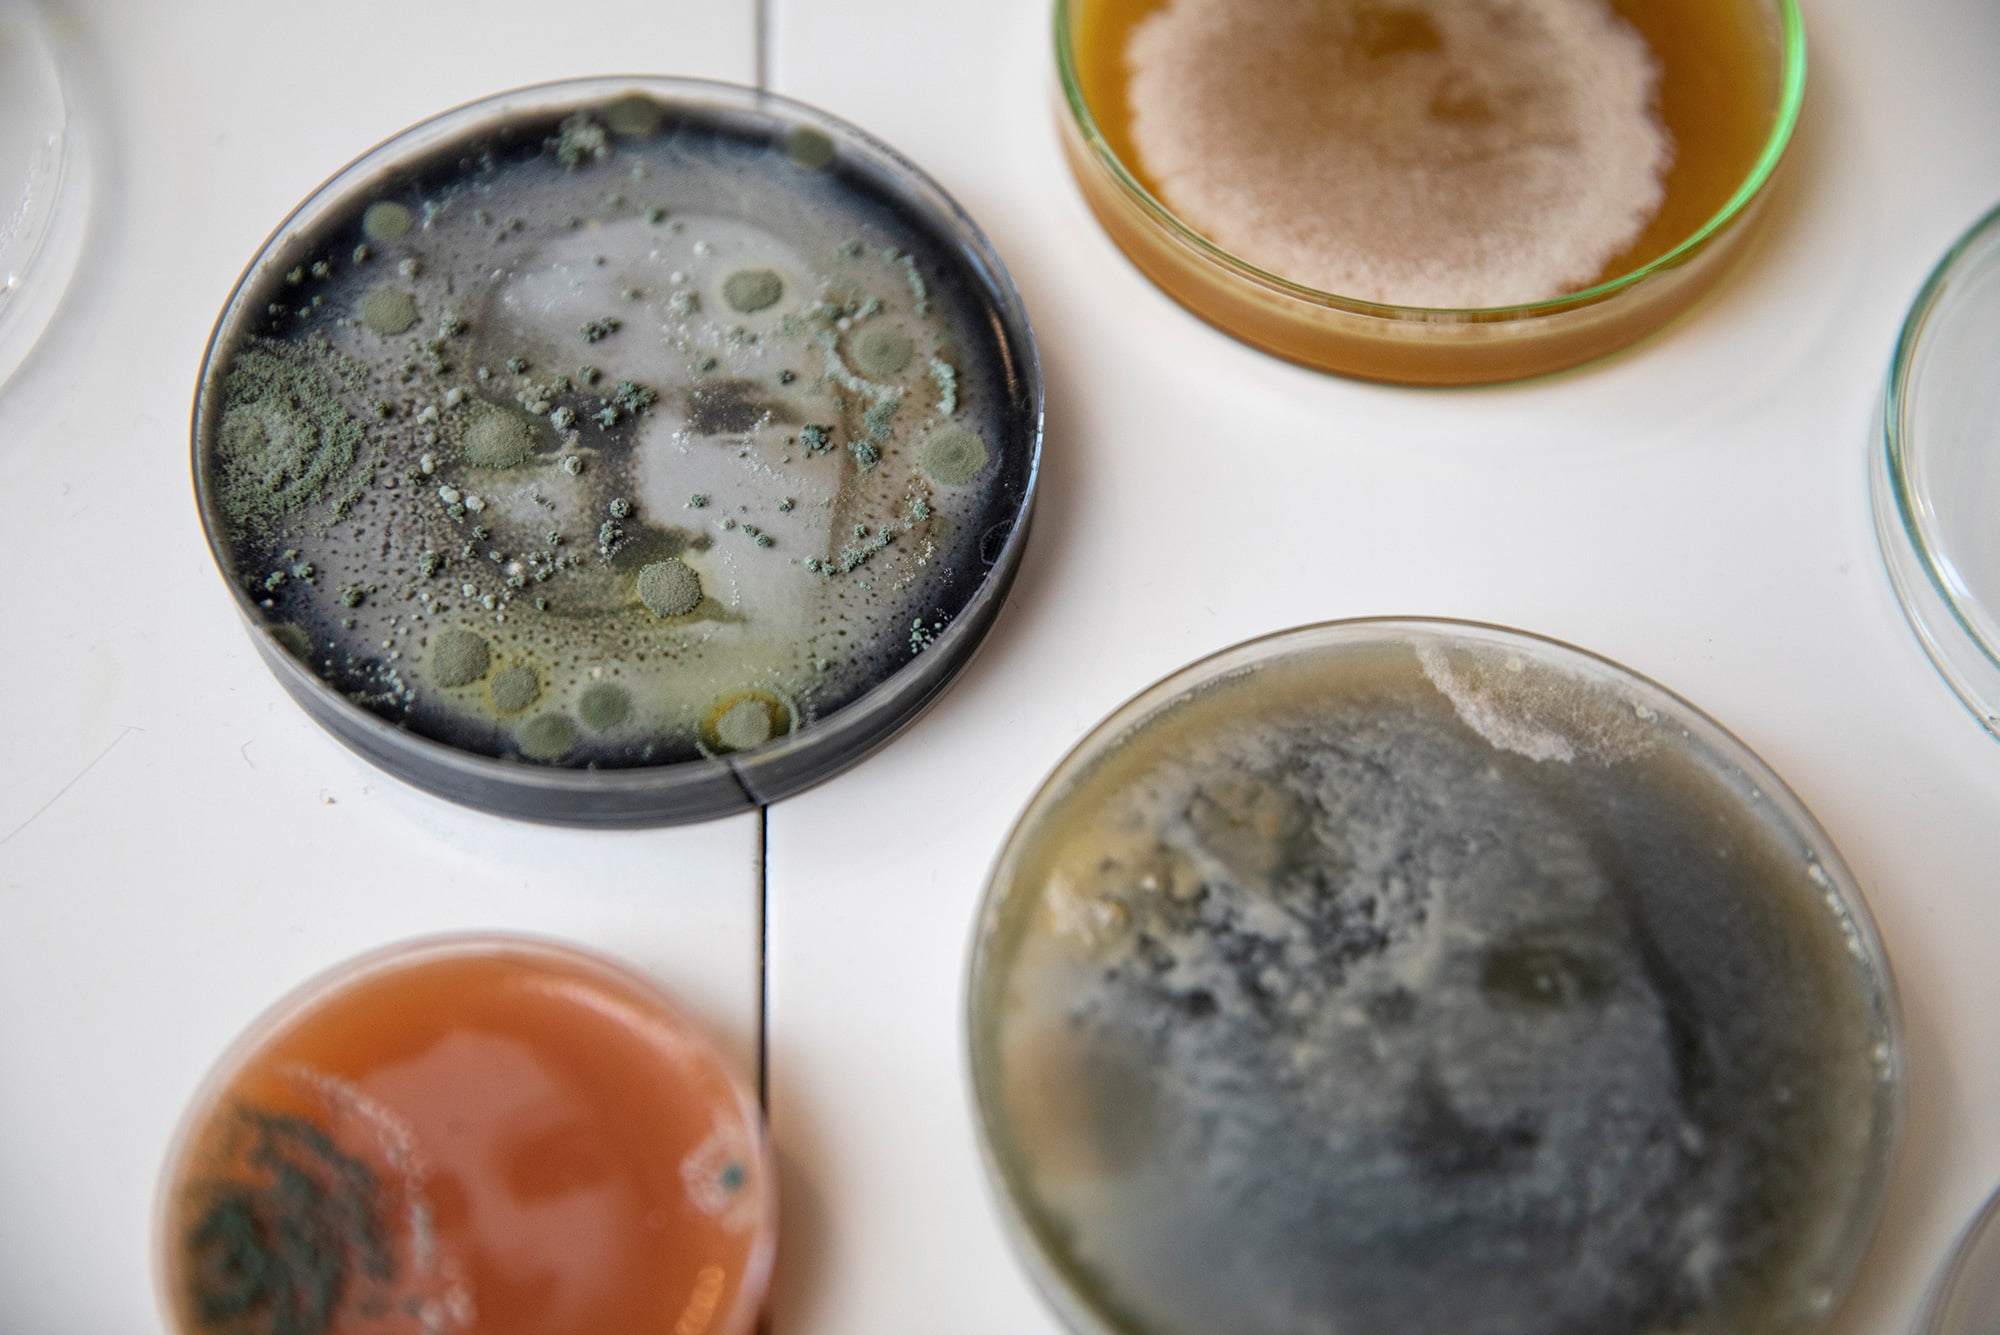

Petrimaljat kuivuvat kauniissa pinossa pyyhkeen päällä keittiössä. Huoneessa on korkea katto ja kaksi jääkaappia. Toisessa on Johanna Rotkon perheen ruokaa ja toisessa monta purkkia täynnä mikrobien avulla tehtyjä kuvia.
Heinolasta kotoisin oleva, Lahdessa nykyään asuva biotaiteilija työskentelee hyötymikrobien, pääasiassa erilaisten hiivalajien, kanssa. Biotaide on luonnontieteitä ja taidetta yhdistelevä taiteenlaji, jossa käytetään usein orgaanista, elävää ainetta. Lääketieteen ja bioteknologian menetelmien soveltaminen on yleistä, ja poikkitaiteellisen tutkimuksen lisäksi taiteenala kehittää kulttuurista keskustelua organismeista ja biologisista prosesseista.
Rotko syttyi biotaiteesta opiskellessaan median laitoksella uutta mediaa Aalto-yliopiston Taiteiden ja suunnittelun korkeakoulussa. Biotaiteen yksikkö biofilian laboratorio perustettiin sinne vuonna 2012, ja Rotko ahmi biofilian kursseista suurimman mahdollisen opintokokonaisuuden.

Yhteistyössä mikrobien kanssa
Töitään Rotko nimittää hiivagrammeiksi. Tähän tekniikkaan hän tutustui Biotaiteen seuran ja Pavillon_35-taiteilijakollektiivin järjestämässä työpajassa vuonna 2013.
Rotko tekee kuvansa yhteistyössä mikrobien kanssa.
”Toisaalta, kuinka hyvä yhteistyökumppani olen, jos tapan hiivasoluja? Jotta kuva syntyy, solujen pitää kuolla tai vahingoittua. Kiinnostavimmat kuvat muodostuvat silloin, kun hiiva tai muut oliot tekevät selvästi oman jälkensä kuvaan pilaamatta sitä minun näkökulmastani käsin.”
Rotko tekee kasvatusalustat hyötymikrobeille vedestä, agar agarista ja sokerista. Hän lisää kasvatusalustaan väriainetta. Rotko käyttää syötäviä väriaineita kuten hiiltä, kurkumaa ja puolukkaa. Tämän jälkeen hän viljelee hyötymikrobit alustoille petrimaljoihin, joiden kansiin tulee erilaisia rasterikuvia. Kuvat ovat valojen alla kahden vuorokauden ajan.
UV-valo tavoittaa ne alueet, jotka eivät jää mustien osien alle. Henkiin jäävät hiivasolut jatkavat kasvuansa myös sen jälkeen, kun ne on otettu pois valojen alta niin pitkään, kun elinolosuhteet ovat niille suotuisat. Kun kuvat ovat kokonaan homerihmastojen peitossa, Rotko siirtää ne biojäteastiaan, pesee petrimaljat ja käyttää ne uudelleen.
”Prosessi vaatii kärsivällisyyttä. Onhan tämä aikamoista luopumista välillä, kun kuva peittyy rihmastojen alle. Mutta siitä pidänkin tässä, kun ikinä ei tiedä, miten teos muuttaa muotoaan. Elämän ja kuoleman symbioosin kamppailussa syntyy kuva.”
Kasvokuvat kertovat valtasuhteista
Rasterikuvissa Rotko käyttää yleensä kasvoja.
”Kasvojen tunnistaminen on ihmisen varhainen kyky. Kasvojen käyttäminen yhdessä mikrobien kanssa kuvastaa valtasuhteita luonnon ja ihmisen välillä. Aluksi lähestymistapani oli hyvin poliittinen: käytin Talvivaaran entisen johtajan Pekka Perän ja Nestlén toimitusjohtajan Peter Brabeck-Lemathen kuvia. Mikrobien kanssa työskentely on muuttanut luontosuhdettani ja avannut oven näkymättömään ja tuntemattomaan mikrobien maailmaan. Luonto voi olla myös ruma, ja se on hyvä niin.”
Rotkon mielestä hiivoissa on valtava potentiaali.
”Hiivalajit ovat kulkeneet mukanamme kymmeniä tuhansia vuosia, mutta silti yhdistämme ne yleensä vain sairauksiin tai pullan leivontaan. On valtavasti hiivalajeja, joista emme tiedä mitään. Hiivoissa on myös potentiaalia esimerkiksi biopolttoaineiden valmistuksessa. UV-valoa voi käyttää desinfiointiin ja spirulinan sukulaisia hiilidioksidin sitojana. Niin scifiltä kuin tämä kaikki kuulostaakin, maailmalla tutkitaan ja hyödynnetään jo näitä prosesseja.”
Johanna Rotkon teoksia esillä Together Alone 2.o -taidenäyttelyssä Espoon Hanasaaren kulttuurikeskuksessa 8.4.-22.5.2022.